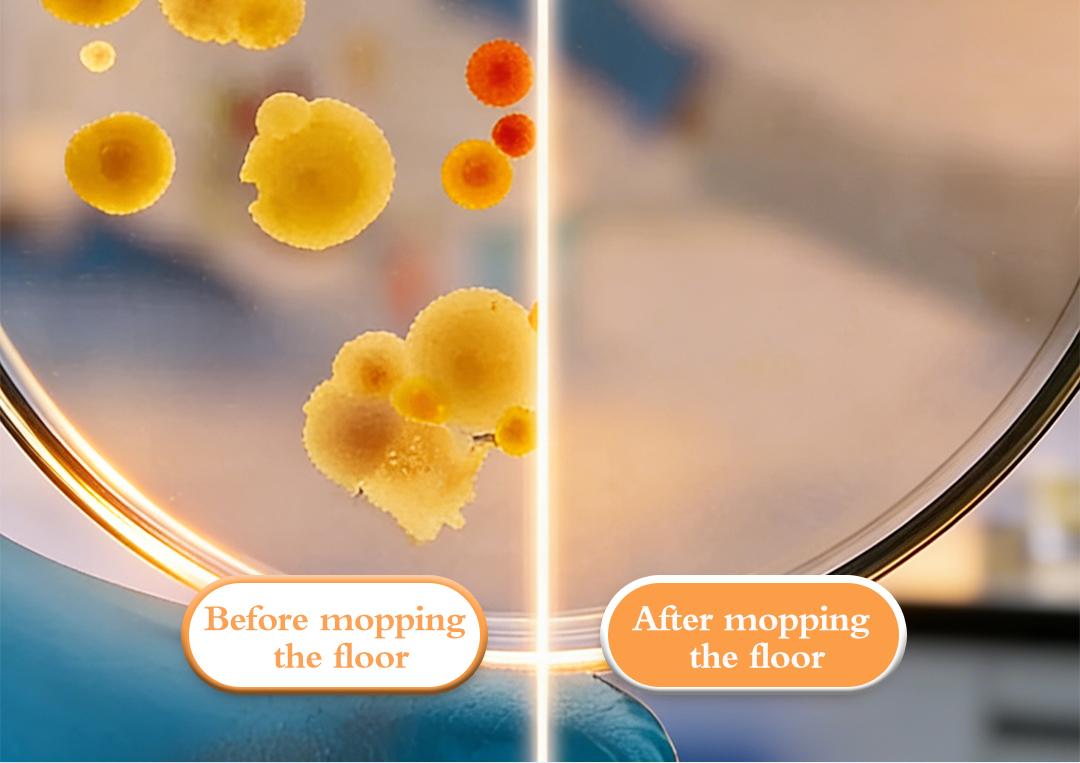
SOPAMI Floor Cleaning Tablets - Safe for Wood Tile Marble Quick Dry No Residue 12 Tablets Lemon Scent SOPAMI Floor Cleaning Tablets - Safe for Wood Tile Marble Quick Dry No Residue 12 Tablets Lemon Scent

Efficient Floor Cleaning Tablets: Multi-Surface Solution (Lemon Scent)
Efficient Floor Cleaning Tablets: Multi-Surface Solution (Lemon Scent)
BUNDLE & SAVE
Couldn't load pickup availability
Share
-
Ordered
- - -
Order Ready
- - -
Delivered

Efficient Floor Cleaning Tablets: Multi-Surface Solution (Lemon Scent)
| Aerosols | No |
| Flammable Liquid | No |

check_box
FAQ
FAQ
FAQ – Frequently Asked Questions
1. When will my order ship?
Most orders are processed within 1–3 business days.
2. How long is delivery?
Standard U.S. delivery usually takes 5–12 business days. International orders may take longer.
3. How do I track my order?
Once your order ships, you will receive an email with a tracking number.
4. Can I change or cancel my order?
Orders can only be changed or canceled before they are shipped. Contact us as soon as possible if you need assistance.
5. What payment methods do you accept?
We accept major credit/debit cards, PayPal, Shop Pay, Apple Pay, and other secure checkout options (depending on availability).
6. What if the item arrived damaged?
Please email us with a photo of the damaged item within 48 hours, and we will arrange a replacement or refund.
7. What if the package is lost?
If your package is marked “delivered” but you didn’t receive it, contact us and we will help investigate with the carrier.
8. Do you ship internationally?
Yes, we ship to most countries. Shipping times vary based on destination.













